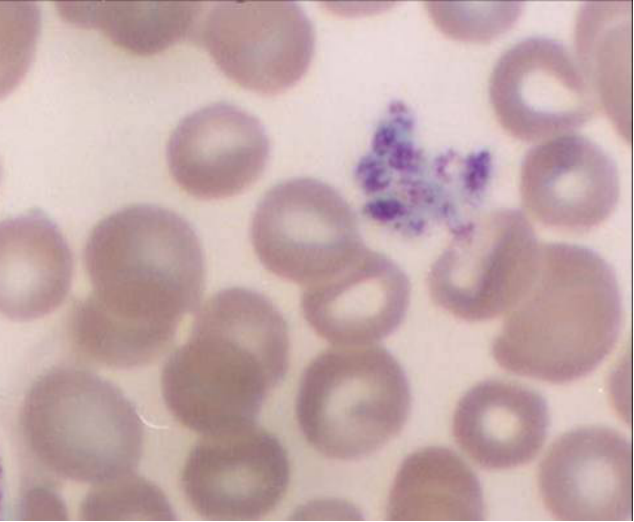

4.3.7 血小板
-
1 内容
-
2 测验
上一节
下一节
来源
骨髓巨核细胞脱落的胞质小块。
形态
1.光镜结构:双凸圆盘状,直径2-4 µm ;受刺激后伸出伪足;在血涂片上常聚集成群;分中央颗粒区和周边透明区。
2.超微结构:颗粒区有特殊颗粒(α颗粒)和致密颗粒,开放小管系和致密小管系;透明区含有微管和微丝。
血小板模式图:

血小板光镜像(Wright-Giemsa,10×40):
功能
● 特殊颗粒含血小板因子Ⅳ、血小板源性生长因子(PDGF)等。
● 致密颗粒含5-羟色胺、钙离子等。
● 参与止血和凝血,促进内皮细胞增殖、修复血管。

